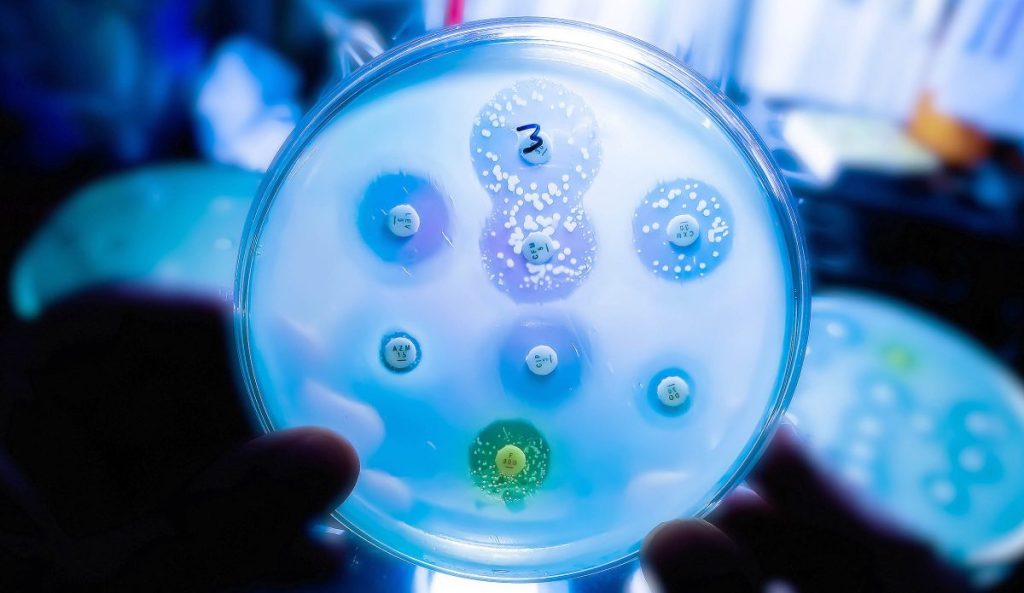

Buttigieg reflects that Biden’s 2024 reelection might have negatively impacted Democrats.

Cedar Rapids, Iowa Pete Buttigieg, who was Transportation Secretary under President Joe Biden, expressed concerns that Biden’s choice to “probably” run for reelection in 2024 has negatively impacted Democrats. During a recent visit to Iowa, he alluded to the idea that Democrats might have fared better if Biden had chosen not to seek a second […]
Kevin O’Leary Drives CNN Panelists Wild After Referring To Kamala Harris As A ‘Loser’

Kevin O’Leary Sparks Debate on CNN On Tuesday, “Shark Tank” star Kevin O’Leary created a stir during a CNN panel discussion. He criticized Kamala Harris’s performance during her 2024 presidential campaign, noting that she lost to then-President Donald Trump after a poor showing in a June debate. O’Leary labeled Harris a “loser,” pointing out that […]
Democrats mock Trump over ‘Qatar-a-lago’

Democrats are set to showcase a banner reading “Qatar a Lago” on Wednesday, following President Trump’s announcement that he would accept a $400 million jet from the Qatari government. Concerns regarding the safety and ethics of the president accepting foreign gifts have been raised by Democrats, political operatives, and some Republicans. “His corruption is an […]
Men in France Contribute 26% More to Carbon Emissions than Women Due to ‘Red Meat and Cars’

A recent French study has indicated a notable “gender gap” in carbon emissions, discovering that women emit 26% less carbon than men, largely due to their dietary and transportation choices. Researchers highlight that family dynamics between genders significantly contribute to the disparity in carbon footprints, with men generally leading the way in France. According to […]
Mexico reduces cruise passenger tax from $42 to $5 following industry objections.

Mexico Lowers Cruise Passenger Tax Amid Industry Concerns The cruise industry faced significant challenges recently, particularly with a new tourism tax affecting passengers. Initially set at $42, this immigration tax for cruise passengers docked in Mexico was approved by the country’s parliament last December. The tax collection was originally scheduled to begin on January 1 […]
Clair Obscur: Expedition 33 is a unique gaming experience unlike any other.

Small Team Behind Gaming Success: Clair Obscur There’s something intriguing about the latest hit in the gaming world, a unique role-playing game titled Clair Obscur: Expedition 33, produced by a small team. They recently celebrated selling 2 million copies, which stands out in a landscape dominated by massive budgets and blockbuster flops. The unassuming team […]
New “superbugs” found in hospitals consume medical plastics
Researchers have found that a well-known hospital bacterium can actually consume the plastics used in sutures, stents, and surgical mesh. This ability allows the microbe to potentially adhere more stubbornly to medical devices and persist longer on surfaces in healthcare settings. A team from Brunel University London, studying a patient-derived strain of Pseudomonas aeruginosa, discovered […]
Comparing Income Tax in MoCo – A Look from Montgomery

When county officials in Montgomery County discuss the possibility of raising income taxes, it’s essential to look at how these taxes compare to those in neighboring regions. Income taxes can be a bit intricate, given the variety, but let’s try to summarize it. Residents here deal with two personal income taxes, along with federal taxes […]
Can you identify this NFL defensive end in today’s trivia challenge?

We’re kicking off another five-day trivia game on SB Nation! If you’re new here, don’t worry—details on how to play are down below. We’d love to hear about your experiences and thoughts, so feel free to share your results. Today’s SB Nation In-5 Game If the game doesn’t show up due to Apple News or […]
Don’t Underestimate America: Charles Payne Claims Price Hikes Are Unrelated to Trump’s Tariffs

On Wednesday, Fox Business host Charles Payne stated that the current high prices of certain products are not a result of President Donald Trump’s tariffs. Recent data from the consumer price index shows that inflation eased to 2.3% annually in April, marking the lowest rate in four years. Payne mentioned during an appearance on Fox […]